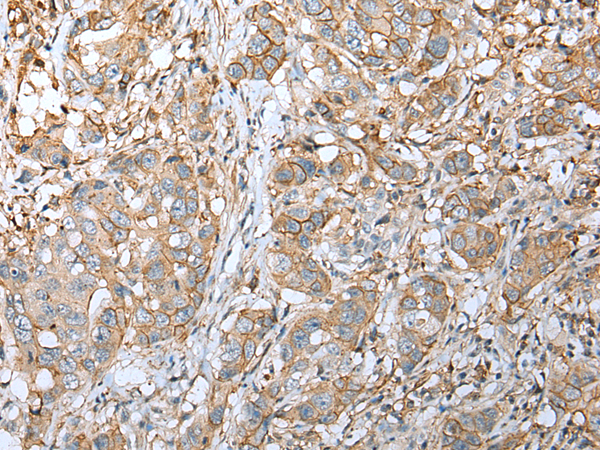
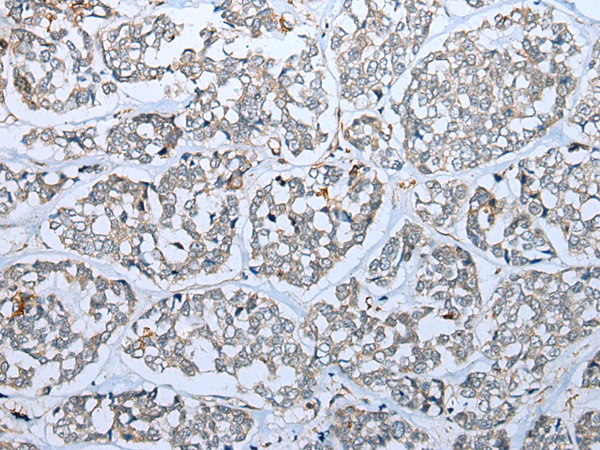
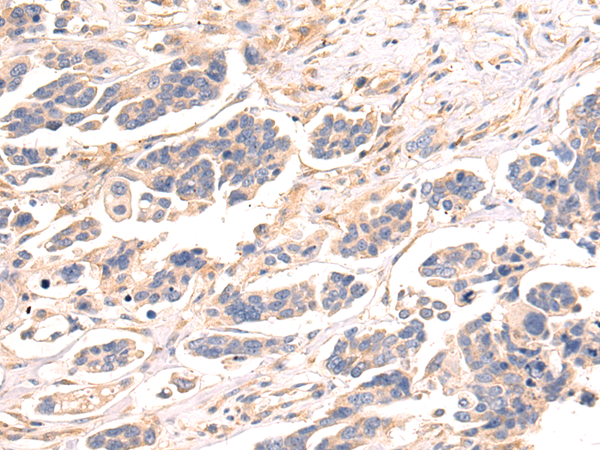

-
分类: 科研抗体货号: P09039别名: FAD104; PRO4979; YVTM2421应用: IHC反应种属: Human, Mouse
-
分类: 科研抗体货号: P09060别名: S15a; DBA20应用: WB,IHC反应种属: Human, Mouse, Rat
-
分类: 科研抗体货号: P09038别名:应用: WB,IHC反应种属: Human
-
分类: 科研抗体货号: P09059别名: KA21; KRT222P应用: IHC反应种属: Human, Mouse
-
分类: 科研抗体货号: P09037别名: B22; LYRM3; CI-B22; UQOR22应用: WB反应种属: Human, Mouse
-
分类: 科研抗体货号: P09058别名: CART应用: WB,IHC反应种属: Human, Mouse, Rat
-
分类: 科研抗体货号: P09036别名: SGDH; CISGDH应用: IHC反应种属: Human
-
分类: 科研抗体货号: P09055别名: GTK; KAT1; KATI; CCBL1应用: WB,IHC反应种属: Human, Rat
-
分类: 科研抗体货号: P09035别名: CI; B17应用: WB,IHC反应种属: Human
-
分类: 科研抗体货号: P09054别名: DBA5; L35A应用: WB,IHC反应种属: Human, Mouse, Rat

鄂公网安备42018502007531号
鄂公网安备42018502007531号

